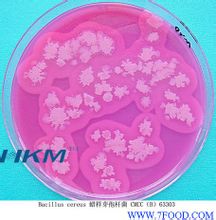
多粘菌素

簡介
 多粘菌素
多粘菌素多粘菌素(polymyxin)是發現於多粘桿菌(Bacillus polymy
xa)培養液中的抗菌性多肽,有A、B、C、D、E等五種。抗菌譜相互類似而範圍寬廣,特別對革蘭氏陰性細菌作用頗強,毒性較弱。口服時不能吸收,但皮下或肌肉注射很快就轉移到血液中去,在3-16小時保持較高的血中濃度。多粘菌素A用於治療幼兒的重症百日咳可獲很好效果。能使金黃色葡萄球菌及大腸桿菌的R型菌體凝集,並形成核糖核酸和不溶性鹽類。多粘菌素B對腎的損害較A、 D兩類為少,因此作為點眼藥應市,對細菌性眼炎有效。
藥物資料
藥用名稱 :多粘菌素
其他名稱 :阿如多粘、多勝菌素乙、硫酸多粘菌素B、嗜氣芽胞菌素
性狀 :注射液。
 多粘菌素
多粘菌素功能主治:主要應
用於綠膿桿菌及其它假單胞菌引起的創面、尿路以及眼、耳、氣管等部位感染,也可用於敗血症、腹膜炎。
用法及用量 1、靜滴:成人及兒童腎功能正常者1日每千克體重1.5-2.5mg(一般每千克體重不超過2.5mg),分成2次,每12小時滴注1次。每50mg本品,以5%葡萄糖液500ml稀釋後滴入。嬰兒腎功能正常者每千克體重可耐受1日4mg的用量。
2、肌註:成人及兒童:1日每千克體重2.5-3mg,分次給予,每4-6小時用藥1次。嬰兒1日量每千克體重可用到4mg,新生兒每千克體重可用到4.5mg。
3、鞘內注射(用於綠膿桿菌性腦膜炎):以氯化鈉注射液製備每毫升藥液含5mg。成人與2歲以上兒童,每日5mg,套用3-4日後,改為隔日1次,至少2周,直至腦脊液培養陰性,檢驗糖量正常。2歲以下兒童,用2mg,每日1次,連續3-4日(或者2.5mg隔日1次),以後用2.5mg,隔日1次,直到檢驗正常。
4、滴眼液濃度每毫升1-2.5mg。
不良反應和注意 1、對腎臟的損害較多見,腎功能不全者應減量。
2、靜注可能招致呼吸抑制,一般不採用。
3、鞘內注射量1效不宜超過5mg,以防引起對腦膜或神經組織的刺激。
4、不應與其他有腎毒性或神經肌肉阻滯作用的藥物聯合套用,以免發生意外。
規格 注射用硫酸多粘菌素B:每瓶50mg(1mg=1000單位)。
藥理套用
 多粘菌素
多粘菌素對綠膿桿菌、大腸桿菌、肺炎克雷白桿菌,以及嗜血桿菌、腸桿菌屬、沙門菌、志賀菌、百日咳桿菌、巴斯德菌和弧菌等革蘭陰性菌有抗菌作用。變形桿菌、奈瑟菌、沙雷菌、普魯威登菌、革蘭陰性菌和專性厭氧菌均對本類藥物不敏感。細菌對本品與多粘菌素e之間有交叉耐藥
性,但對本類藥物與他類抗菌藥物間則沒有交叉耐藥性發現。
口服不吸收。注射後主要由尿排出,但在12小時內僅排出很少量,以後可達到20~100μg/ml濃度。停藥以後1~3天內,繼續有藥物排泄。
主要套用於綠膿桿菌及其他假單胞菌引起的創面、尿路以及眼、耳、氣管等部位感染,也可用於敗血症,腹膜炎。
功用作用
對綠膿桿菌、大腸桿菌、肺炎克雷白桿菌,以及嗜血桿菌、腸桿菌屬、沙門菌、志賀菌、百日咳桿菌、巴斯德菌和弧菌等革蘭陰性菌有抗菌作用。
變形桿菌、奈瑟菌、沙雷菌、普魯威登菌、革蘭陰性菌和專性厭氧菌均對本類藥物不敏感。細菌對本品與多粘菌素E之間有交叉耐藥性,但對本類藥物與他類抗菌藥物間則沒有交叉耐藥性發現。
 多粘菌素
多粘菌素口服不吸收。注射後主要由尿排出,但在12小時內僅排出很少量,以後可達到20~100μg/ml濃度。停藥以後1~3天內,繼續有藥物排泄。
主要套用於綠膿桿菌及其他假單胞菌引起的創面、尿路以及眼、耳、氣管等部位感染,也可用於敗血症、腹膜炎。
用法用量
(1)靜滴成人及兒童腎功能正常者1日1.5~2.5mg/kg(一般不超過2.5mg/kg),分成兩次,每12小時滴注1次。每50mg本品,以5%葡萄糖液500ml稀釋後滴入。嬰兒腎功能正常者可耐受1日4mg/kg的用量。
多粘菌素
多粘菌素(2)肌注成人及兒童:1日2.5~3mg/kg,分次給予,每4~6小時用藥1次。嬰兒1日量可用到4mg/kg,新生兒可用到4.5mg/kg。
(3)鞘內注射(用於綠膿桿菌性腦膜炎)以氯化鈉注射液製備5mg/ml藥液。成人與2歲以上兒童,每日5mg,套用3~4日後,改為隔日1次,至少2周,直至腦脊液培養陰性,檢驗糖量正常。2歲以下兒童,用2mg,每日1次,連續3~4天(或者2.5mg隔日1次),以後用2.5mg,隔日1次,直到檢驗正常。
(4)滴眼液濃度1~2.5mg/ml。
體內過程
多粘菌素口服不易吸收。肌內注射50mg後2小時血藥濃度達峰值(2~8mg/L),有效血藥濃度可維持8~12小時,t1/2約6小時。腎功能不全者清除慢,t1/2可達2~3天。它分布於全身組織,以肝、腎為最高,並保持較長時間。多粘菌素不易彌散進入胸、腹腔、關節腔,即使在腦膜炎症時也不易透入 腦脊液中, 膽汁中濃度也較低。藥物經腎緩慢排泄。
臨床套用
 多粘菌素
多粘菌素對多數革蘭陰性桿菌有殺滅作用。多肽類抗生素具有表面活性,含有帶陽電荷的游離氨基,能與革蘭陰性菌細胞膜的磷
脂中帶陰電荷的磷酸根結合,使細菌細胞膜面積擴大,通透性增加,細胞內的磷酸鹽、核苷酸等成份外漏,導致細菌死亡。多粘菌素對生長繁殖期和靜止期的細菌都有效,過去曾用於對其他抗生素耐藥的綠膿桿菌和革蘭陰性桿菌所致感染如敗血症、腦膜炎、心內膜炎、燒傷後感染等。但現在已被療效好、毒性低的其他抗生素所取代。仍可局部用於敏感菌的眼、耳、皮膚、黏膜感染及燒傷綠膿桿菌感染。多粘菌素口服用於腸道手術前準備。
不良反應
毒性較大。主要表現在腎臟及神經系統兩方面,其中多粘菌素B較E尤為多見,症狀為 蛋白尿、血尿等。大劑量、快速靜脈滴注時,由於神經肌肉的阻滯可導致呼吸抑制。
治療案例
細菌性腦膜炎的治療
(1)B組 鏈球菌腦膜炎的治療,建議用 青黴素G每日50萬u/kg或氨卡青黴素每日300-400mg/kg,加上 慶大黴素每日0.75mg/kg。革蘭氏陰性桿菌腦膜炎治療較為困難,典型的用藥氨卡青黴素加一種氨基糖甙類藥物死亡率達20%-30%。第三代頭孢菌素(如頭孢氨噻)是治療已證實的革蘭氏陰性桿菌腦膜炎(或敗血症)或那些肯定的敗血症的首選藥物。腦膜炎的特殊臨床情況也影響抗生素的選擇,例如生後一周內懷疑有敗血症而給予氨苄青黴素和慶大黴素治療的新生兒,以及出生幾周后發生 敗血症和腦膜炎者應合併使用萬古黴素及與以前不同類型的氨基糖甙類(如 丁胺卡那黴素)或第三代頭孢菌素(例如頭孢氨噻), 多粘菌素B等藥物。
(2)病兒年齡對抗生不經選擇有一定的指導意義,如年長兒童患 流感桿菌腦膜炎較少,新生兒化腦大多數是腸道革蘭氏陰性桿菌的藥物。一般主張用一般氨其糖類藥物甙類青黴素,因慶大黴素、丁胺卡那黴素對腸道革蘭氏陰性桿菌有效,而青黴素對鏈球菌、 肺炎鏈球菌、腦膜炎雙球菌均有效。也可選用氨苄青黴素這一廣譜抗生素代替青黴素,耐藥菌株可用按苄青黴素加頭孢氨噻肟。新生兒尤其未成熟兒一般忌用氯黴素,因其肝、腎發育尚未成熟,對 氯黴素的代謝、排泄功能尚不健全,易引起中毒,表現為“灰嬰綜合徵”,甚至休剋死亡。
(3)保證藥物在腦脊液中達到有效濃度:首先應選用易於透過血腦屏障的藥物,使腦脊液中抗生素濃度超過抑菌濃度10倍以上。並要注意給藥方法及用藥劑量。 氯黴素、 磺胺嘧啶、靜注 甲氧苄氨嘧啶(TMP)能較好到達腦脊液,保持有效的抗菌濃度,特別是氯黴素也較多通過發炎的腦膜。腦膜通透性隨病情好轉逐漸恢復正常,因而繼續進入腦脊液的藥量亦隨之減少。為保證治療效果,需大劑量由靜脈給藥,直到療程結束,不可中途減量及改變給藥方法。
紅黴素養、 羧苄青黴素、萬古黴素、1~2代頭孢菌素、氨基糖酐類抗生素通過血腦屏障的能力能較差,這時候使用多粘菌素B就有較好的效果。
(4)如果選用的藥物能很好通過血腦屏障,原則上不需鞘內注射,以免出現不良反應及增加病兒痛苦慶大黴素、丁胺卡那黴素等藥不易到達腦脊液,可採用鞘內或腦室注射給藥。對延誤診治的嬰兒晚期化腦,腦脊液外觀有膿塊形成,或細菌對 抗生素耐藥時,加用鞘內注射抗生素可提高治癒率。根據抗生素在腦脊液中 存留時間,每日或隔日注射一次,一般連用3~5次,直到 腦脊液轉為清晰,細胞數明顯下降,細菌消失。對葡萄糖球菌或少見細菌存在,或鞘注3~5次後腦脊液仍呈明顯炎症改變時,則可延長鞘內注射時間,甚至可連續給7~10次。進行鞘內注射時,藥物必須稀釋至一定濃度,可用抽出之腦脊液或 生理鹽水稀釋,需注意注入液量應略少於放出之腦脊液量。注射速度應緩慢。 針對細菌性腦膜炎,藥物治療中使用氨基糖甙類藥物,或者配合多粘菌素B的治療效果理想。
製劑用法
硫酸鏈黴素(streptomycinsulfate)成人0.75~1.0g/日,兒童15~30mg/kg/日,分1~2次肌內注射。成人1~3g/日,兒童1mg/kg/日,分4次服。 硫酸慶大黴素(gentamicinsulfate)成人16~24萬單位/日,兒童3,000~5,000u/kg/日,分3~4次肌內注射。靜脈滴注劑量同上,忌與青黴素等混合滴注。鞘內注射,成人每次5,000~10,000單位。口服,成人24萬~64萬單位/日,兒童1萬~1.5萬單位/kg/日,分四次服。
硫酸卡那黴素(kanamycinsulfate)成人1.0~1.5g/日,兒童20~30mg/kg/日,分2~3次肌內注射。靜脈滴注用,劑量同肌內注射。療程一般不超過10~14天。
硫酸妥布黴素(tobramycinsulfate)成人或兒童每次1.5mg/kg/日,每8小時一次,肌內或靜脈注射,總量不超過5mg/kg/日,療程一般不超過10~14天。
硫酸阿米卡星(amikacinsulfate)成人1.0~1.5g/日,分2~3次肌內注射。
硫酸西索米星(sisomicinsulfate)全身性感染用3mg/kg/日,分3次肌內注射,尿道感染可按2mg/kg/日,分2次肌內注射。
硫酸奈替米星(netilimicinsulfate)成人用4~6mg/kg/日,嚴重感染7.5mg/kg/日,分2~3次肌內注射;兒童按6~7.5mg/kg/日,分3次給予。
硫酸新黴素(neomycinsulfate)成人1~4g/日,兒童25~50mg/kg/日,分4次口服。
大觀黴素(spectinomycin)2g溶於3.2ml特殊稀釋液(0.9%苯甲醇溶液)深部肌注,每日1~2次。
硫酸多粘菌素B(polymyxinBsulfate)成人50~100萬單位/日,兒童1.0~2.0萬單位/日,分2~3次肌內注射或靜脈滴注,療程一般不超過7~14天,鞘內注射,成人1萬單位/次,兒童5,000單位/次。
硫酸多粘菌素E(polymyxinEsulfate,colistinsulfate)肌內注射,成人100~150萬單位/日,兒童1.5~2.5萬單位/kg/日,分2~3次。靜脈滴注,成人50~100萬單位/日,分2次;兒童1.5~2.5萬單位/kg/日,分1~2次。療程一般不超7天。口服,100~200萬單位/日,分3~4次服。

